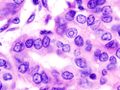
Micrograph (high power view) of PTC demonstrating nuclear clearing and overlapping nuclei. H&E stain.

سرطان الغدة الدرقية الحليمي
| سرطان الغدة الدرقية الحليمي Papillary thyroid cancer | |
|---|---|
 | |
| سرطان الغدة الدرقية الحليمي. | |
| التخصص | جراحة الأنف والأذن والحنجرة |
سرطان الغدة الدرقية الحليمي[1]، هو أكثر أنواع سرطانات الغدة الدرقية شيوعاً،[2] ويمثل 75-85% من جميع حالات سرطان الغدة الدرقية.[1] يحدث بشكل أكثر تواتراً بين النساء وأكثر شيوعاً في الفئة العمرية 20-55. وهو أيضاً نوع السرطان السائد لدى الأطفال المصابين بسرطان الغدة الدرقية، ولدى مرضى سرطان الغدة الدرقية الذين تعرضوا لإشعاعات سابقة في الرأس والعنق.[3] وعادة ما يكون عالي التمايز، بطيء النمو، ومتمركز، على الرغم من إمكانية انتقاله لأماكن أخرى في الجسم.
التشخيص
عادة ما يكتشف سرطان الغدة الدرقية الحليمي أثناء الفحص الروتيني للعقيدة الدرقية عديمة الأعراض التي تظهر كتضخم في العنق. في بعض الحالات، قد يتسبب التضخم في ظهور بعض الأعراض الموضعية. لفحص هذا التضخم تُجرى الخزعة المشفوطة بالإبرة. نتائج الخزعة بالإبرة بالغة الدقة وهو إجراء يشيع استخدامه في هذه الحالات.وتتضمن وسائل الفحص الأخرى التصوير بالموجات فوق الصوتية والمسح النووي. الموجات فوق الصوتية اختبار مفيد للتمييز بين الآفات الصلبة والكيسية ولتحديد التكلسات.[4] كما يعتبر التصوير بالموجات فوق الصوتية للغدة الدرقية إجراءاً فعالاً للغاية لاكتشاف السرطانات الدقيقة، التي تكشف عن السرطانات شديدة الصغر (<1 سم).
كما يكتشف سرطان الغدة الدرقية الحليمي عند اكتشاف عقيدة صلبة في حالة تضخم الدرقية متعدد العقيدات، عند التحقق من تضخم العقيدات اللمفاوية القحفية، أو عند وجود آفات نقيلية غير محددة في أماكن أخرى بالجسم.[5] ينبغي فحص الآفات المنتشرة الموجودة في الغدة الدرقية، خاصة إذا كانت مؤلمة، لأنها قد تشير إلى وجود سرطان الغدة الدرقية الحليمي. العلامات السريرية الأخرى التي يمكن أن تشير إلى الغدة الدرقية الحليمية هي تصلب القصبة الهوائية، وجود تكتلات حادة بالرقبة، تضرر بالأعصاب الودية الحنجرية الراجعة أو القحفية. قد تظهر لدى خمسة بالمائة من السكان عقيدات درقية، لكن معظمها تكون حميدة.[6]
تتضمن المتابعة المناسبة الموجات فوق الصوتية على الرقبة، تليها الدراسات المعملية. يلتقي المرضى عادة مع أخصائي الغدد الصماء والجراح (جراح الرأس والعنق أو جراح الغدد الصماء).
الدلالات
قد يستخدم الثيروگلوبين كدلالة أورام للكشف سرطان الغدة الدرقية الحليمي شديد التمايز.[7][8] قد تكون صبغة HBME-1 مفيدة لتمييز السرطان الحليمية عن السرطانات الجريبية؛ حيث يكون إيجابياً في حالة الآفات الحليمية.[9]
انخفاض تعبير انزيم ATP5E يرتبط بشكل ملحوظ بتشخيص سرطان الغدة الدرقية الحليمي وقد يستخدم كدلالة أورام للمرض.[10]
علم الأمراض
اسم سرطان الغدة الدرقية الحيمي مشتق من الحليمات الموجودة في خلاياه السرطانية، والتي تُرى تحت المجهر. وتتضمن الخصائص المميزة:
- Characteristic Orphan Annie eye nuclear inclusions (nuclei with uniform staining، التي تظهر فارغة بسبب الكروماتين ومساحيق النوى[11] and psammoma bodies on light microscopy. The former is useful in identifying the follicular variant of papillary thyroid carcinomas.[12]
- الانتشار اللمفاوي أكثر شيوعاً عن الانتشار دموي المنشأ
- التعددية البؤرية شائعة
- Lateral Aberrant Thyroid الشهير هو في الواقع انبثاث عقدي لمفي من سرطان الغدة الدرقية الحليمي.[13]
- السرطانة الحليمية الدقيقة هي مجموعة فرعية من سرطان الغدة الدرقية الحليمي وتُعرف بأنها سرطانة بقياس أقل من أو يساوي 10 سم.[14] أعلى معدل لسرطانات الغدة الدرقية الحليمية الدقيقة ظهر في سلسلة خزعات أبلغ عنها هاراتش وزملائه عام 1985، والتي عُثر عليها في 36 من 101 خزعة متوالية للعثور على سرطانة دقيقة عرضية.[15] أبلغ مايكل پاكدامان وزملائه عن أعلى معدل في سلسلة جراحات استرجاعية بنسبة 49.9% ضمن 860 حالة.[16] استراتيجيات إدارة السرطان الحليمي العرضي باستخدام الموجات فوق الصوتية (والمؤكدة بواسطة FNAB) في نطاق يتراوح من استئصال الغدة الدرقية الكلي مع الاجتثاث باليود المشع إلى المراقبة وحدها. هاراتش وآخرون. أقترح استخدام المصطلح "الورم الحليمي الغامض" لتجنب مضايقة المرضى بسبب الإصابة بالسرطان. كان وولنر وزملائه أول من صاغوا اعتباطياً مصطلح "السرطان الحليمي الغامض" عام 1960، لوصف السرطانات الحليمية بقطر ≤ 1.5 سم.[17] تم تحديد العديد من المتغيرات، على الرغم من أن سرطان الغدة الدرقية الحليمي الكلاسيكي هو الأكثر شيوعاً؛ المجهرية، البديل المسامي، متغير التصلب المنتشر، متغير الخلية طويل القامة، متغير الخلية العمودية، متغير hobnail، من بين أشياء أخرى. تم إعادة تصنيف المتغير الجريبي المغلف، على وجه التحديد عندما يكون منتشراً، [أورام الغدة الدرقية المسامية الغير منتشرة ذات السمات النووية الحليمية|ورم الغدة الدرقية المسامي الغير منتشر ذو السمات النووية الشبه-حليمية]].[18]
على الرغم من ميل السرطان الحليمي لغزو الأوعية اللمفاوية، إلا أنه ميلاً لغزو الأوعية الدموية.[19] هذه الأنواع من الأورام هي أكثر الأورام الغير مغلفة شيوعاً، ولديها ميل كبير للانتشار موضعياً إلى الغدد الليمفاوية، والتي قد تنتج الهياكل الكيسية بالقرب من الغدة الدرقية والتي يصعب تشخيصها بسبب قلة الأنسجة الخبيثة.[5][20] علاوة على ذلك، قد تنتقل الأورام الحبيبية إلى الرئتين لينتج عنها بضعة عقيدات أو قد تعطي أنسجة الرئتين مظهر ندفات الثلج.
ومن الخصائص الأخرى للسرطان الحليمي زيادة المتقدرة، زيادة RER، وكذلك زيادة الزغيبات القمية. علاوة على ذلك، تتميز السرطانات الحليمي بنمواً بطيئاً، وفي 40% من الحالات ينتشر السرطان خارج الكبسولة.[21]
Micrograph of papillary thyroid carcinoma demonstrating prominent papillae with fibrovascular cores. H&E stain.
Micrograph of metastatic papillary thyroid carcinoma to a lymph node. H&E stain.
Micrograph of papillary thyroid carcinoma, tall cell variant - high magnification. H&E stain.
الطفرات المرتبطة
الطفرات المرتبطة بسرطان الغدة الدرقية الحليمي تأخذ شكلين أساسين للانتقال الكروموسومي وشكلاً واحداً للطفرة النقطية. تؤدي هذه التعديلات إلى تفعيل مسارالتسرطن-MAPK/ERK pathway المشترك.
تتضمن الانتقالات الكروموسومية RET proto-oncogene (ترميز مستقبل كيناز التايروسين الذي يلعب دوراً أساسياً في تطور الخلايا العصبية الصماء) الواقعة على الكروموسوم 10q11 والتي تحدث في حوالي خمس حالات سرطان الغدة الدرقية الحبيبي. اندماج الپروتينات الورمية المولدة ينتج عنه ما يسمى پروتينات RET/PTC proteins (ret/papillary thyroid carcinoma), and constitutively activate RET and the downstream MAPK/ERK pathway.[1] تواتر انتقال ret/PTC يكون أعلى بكثير في السرطانات الحليمية لدى الأطفال وبعد التعرض للإشعاع.[1] الجين NTRK1 (يرمز مستقبل TrkA)، يقع على الكروموسوم 1q، يتم نقلها بالمثل في حوالي 5% إلى 10% من سرطانات الغدة الدرقية الحليمي.[1]
ما يقرب من ثلث إلى نصف حالات سرطان الغدة الدرقية الحليمية سببها طفرات نقطية في الجين الورمي BRAF، وكذلك تنشيط المسار MAPK/ERK.[1] في هذه الحالات وجدت أن طفرات e BRAF كانت تتضمن طفرة V600E. بعد إجراء التحليل متعدد المتغيرات، وجد أن غياب كبسولة الورم هو المعامل الوحيد المرتبط (P=0.0005) بالطفرة BRAF V600E.[5] حسب الدراسات الحديثة، فإن السرطانات الحليمية تحمل طفرة V600E الشائعة ذات الطبيعة الأكثر عدوانية على المدى الطويل. طفرات BRAF هي طفرات شائعة في السرطان الحليمي وفي السرطانات الغير متمايزة التي تطورت من الأورام الحليمية.
العلاج
تبقى الجراحة الدعامة الأساسية لعلاج سرطان الغدة الدرقية الحليمي. تنص الطبعة المنقحة لإرشاجات الجمعية الأمريكية للغدة الدرقية لعام 2009 حول سرطان الغدة الدرقية الحليمي على أن الإجراء الأولي يجب أن يكون استئصال الغدة الدرقية شبه الكلي أو الكلي. استئصال الفص الدرقية وحده قد يكون علاجاً كافياً لسرطان الغدة الدرقية الحليمي الصغير (1 سم)، منخفض الخطورة، أحادي البؤرة، في حالة عدم وجود انبثاث سابق في الرأس والعنق أو تورم عقدي قحفي تم اكتشافه إشعاعياً أو سريرياً.[22]
- الأورام الصغرى (قطر يصل إلى 1.0 سم) - استئصال الدرقية الجزئي (أو استئصال الفصوص أحادية الجانب) واستئصال البرزخ قد يكون كافياً. هناك بعض النقاش حول ما إذا كان هذا لا يزال من الأفضل لهذه المجموعة من المرضى استئصال الغدة الدرقية كلياً.
- الأورام الجسيمة (بقطر أكثر من 1.0 سم) - استئصال الدرقية بالكامل، وإزالة العقدة اللمفاوية المركزية كخيار للعلاج. كما يمكن إزالة العقد العنقية الخارجية في الوقت نفسه إذا كان الموجات فوق الصوتية الموجهة FNA والمسح السرطاني بالثيروگلوبولين للعقيدات العنقية كان إيجابياً في مرحلة ما قبل الجراحة.
أسباب استئصال الغدة الدرقية كلياً:[23]
- تقليل خطر الانتكاسات، إذا تمت إزالة العقيدات المركزية في الجراحة الأصلية.
- 30-85% من السرطانات الحليمية هي مرض متعدد البؤر. قد يؤدي اسئتصال الدرقية الجزئي لترك أوراماً في فصوص أخرى من الغدة الدرقية. ومع ذلك، فإن المرض متعدد البؤر في الفص الباقي قد لا يصبح بالضرورة ذو أهمية سريرية أو يشكل خطراص في بقاء المريض على قيد الحياة.
- سهولة المراقبة باستخدام هرمون الغدة الدرقية (تزداد حساسية الكشف عن الانتكاسات في وجود استئصال الغدة الدرقية الكلي، واستئصال ما تبقى من الغدة الدرقية بجرعة منخفضة اليود المشع] 131 بعد اتباع نظام غذائي منخفض اليود (LID).
- سهولة الكشف عن الأمراض النقيلية عن طريق الموجات فوق الصوتية على الدرقية والعنق.
- مضاعفات ما بعد العمليات الجراحية في مراكز جراحة الغدة الدرقية المرموقة والتي تضم جراحين ذوي خبرة مماثلة لتلك الخاصة باستئصال الغدة الدرقية الجزئي.
- أسباب إزالة الغدة الدرقية الجزئي:
- مع التشخيص الجيد ينخفض معامل خطر السرطان للمرضى، حيث نتائج البقاء على قيد الحياة تكون مماثلة لدى المرضى المعرضين للخطر والذين خضعوا لاستئصال الغدة الدرقية الكلي مقابل استئصال الدرقية الجزئي.
- تقل احتمالية خضوع المريض للعلاج بالهرمونات البديلة للدرقية مدى الحياة فيما بعد الجراحة.
- في حالة الانتكاسات، فحوصات الجسم الكلية للغدة الدرقية أقل موثوقية في عثورها على الأورام من TG والموجات فوق الصوتية.
الأورام الحليمية تكون أكثر شراسة لدى المرضى أكبر من 45 سنة. في مثل هذه الحالات، قد يتطلب العلاج إجراء استئصال أكبر والذي يشمل إزالة أجزاء من القصبة الهوائية. كذلك، قد تزال العضلة القصية الترقوية الحلمية، الوريد الوداجي، والعصب الإضافي إذا كانت هذه الأجزاء ضرورية لاستئصال الورم بالكامل. إذا تبقت أجزاء من الورم في العنق، فيوصي بالعلاج الإشعاعي الخارجي وقد أثبت أنه مفيد خاصة في تلك الحالات التي لا يستجيب فيها الورم المتبقي للعلاج باليود المشع.
بعد إزالة الغدة الدرقية جراحياً، ينتظر المريض لحوالي 4-6 أسابيع ثم يبدأ العلاج باليود المشع. يهدف هذا العلاج إلى التحقق والقضاء على أي انبثاث والأنسجة المتبقية في الدرقية. قد يُكرر العلاج بعد 6-12 شهر من العلاج الأولي للمرض النقيلي في حالة عودة المرض أو عدم استجابته للعلاج بشكل كامل.[24]
يخضع المرضى بعد الجراحة للعلاج بالهرمونات البديلة مدى الحياة مثل اللڤوثيروكسين levothyroxine، وخاصة بعد استئصال الدرقية الكلي. أثبت العلاج الكيميائي باستخدام السيسپلاتين cisplatin أو الدوكسوروبيسين doxorubicin فعالية محدودة، مع ذلك، قد يكون مفيداً للمرضى المصابون [[انبثاث عظمي|بانبثاثات عظميةي] أو يحسن جودة حياتهم. كما يوصف للمرضى بعد الجراحة العلاج باللڤوثيروكسين واليود المشع. يؤثر اللڤوثيروكسين على نمو ونضوج الأنسجة ويساهم في عملية النمو، الأيض والتطور بشكل طبيعي. في حالات الانبثاث، قد يوصى بتناول المرضى أدوية مضادة للأورام التي تثبط نمو الخلية وتساعد في تخفيف الأعراض الحليمية في الحالات المتقدمة من المرض.
بعد نجاح العلاج، قد تصاب 35% من الحالات بانتكاسات في غضون 40 عام. كذلك، قد يعاني المرضى من ارتفاع معدل ظهور نقيلات العقيدية، حيث يظهر لدى 35% من المرضى نقيلات عقدية قحفية. حوالي 20% من الحالات تتطور لديهم الأورام المتعددة داخل الغدة الدرقية.[25]
هناك نقاش مستمر حول أفضل ادارة فيما يخص الإجراء الجراحي الأمثل لسرطان الغدة الدرقية الحليمي. وُجد أن تشخيص المرضى الذين يعانون من سرطان الغدة الدرقية الحليمي يعتمد على عمر المريض، وحجم الورم، ووجود مرض نقيلي، وغزو الورم للأنسجة المجاورة بالقرب من الغدة الدرقية. بحثت الدراسات الحديثة مقاربة أكثر تحفظاً للجراحة وأظهرت أن استئصال الغدة الدرقية قد يكون مقبولاً للمرضى الذين يعانون من سرطان الغدة الدرقية الحليمي منخفض الخطورة بورم يتراوح حجمه من 1 سم إلى 4 سم مع عدم وجود غزو للأنسجة المحيطة بالغدة الدرقية أو ورم خبيث. خلصت الدراسات التي تفحص قواعد البيانات الكبيرة للمرضى المصابين بسرطان الغدة الدرقية الحليمي إلى أنه لا توجد ميزة للبقاء على قيد الحياة بالنسبة للمرضى الذين يعانون من المرحلة الأولى من سرطان الغدة الدرقية الحليمي بأورام يصل حجمها إلى 1-4 سم عن الذين خضوا للاستئصال الكلي للغدة الدرقية مقابل الاستئصال الجزئي للدرقية.[26] في ضوء هذه البيانات، فإن اختيار المسار الأمثل للإدارة الجراحية والطبية لسرطان الغدة الدرقية الحليمي يجب أن يشمل اتخاذ القرارات بصفة مشتركة من المرضى وأخصائي الغدد الصماء والجراحين.
توقعات سير المرض
تبعاً للمصدر، فإن المعدل الإجمالي للبقاء خمس سنوات في حالات سرطان الغدة الدرقية الحليمي يبلغ 96%[27] أو 97%،[28] حيث يبلغ معدل البقاء لعشر سنوات 93%.[27]
لتوقعات أكثر تحديداً لسير المرض فيما يخص الحالات الفردية، يوجد ما لا يقل عن 13 نظاماً معروفاً لتوقعات سير المرض؛ وأكثرها استخداماً:
- AGES -العمر، الدرجة، انتشار المرض، الحجم
- AMES - العمر، الانبثاث، انتشار المرض، الحجم
- MACIS - الانبثاث، عمر المريض وقت الإصابة، اكتمال الاستئصال الجراحي، الانتشار (خارج الدرقية)، الحجم[29] (وهو تعديل لنظام AGES). قد يكون الأسلوب المتاح الأكثر موثوقية لتحديد مرحلة المرض. كما يُعرف بنظام MAICS.
- TNM staging - الورم، العقدة، الانبثاث. ملحوظة حول تحديد مرحلة السرطان بنظام TNM فيما يخص سرطان الغدة الدرقية (المتمايز) هو أن النقاط تختلف حسب العمر.
MACIS
نظام MACIS لتقدير توقعات سير سرطان الغدة الدرقية الحليمي، طوره كليڤ س. گرانت في مايو كلينيك، وتستند إلى التقدير الدقيق لمجموعة كبيرة من المرضى. ويرجح أنها أكثر وسائل تحديد مراحل المرض المتاحة موثوقية.[30]
يعين النظام درجات للعوامل الرئيسية المعنية، ويستخدم مجموع هذه النتيجة لحساب توقعات سير المرض:
| العوامل[30] | النقاط[30] | |
|---|---|---|
| Metastasis الانبثاث المتباعد: انتشار السرطان في مناطق أخرى خارج العنق | نعم | 3 |
| لا | 0 | |
| Age العمر عند اكتشاف الورم | أقل من 39 سنة | 3.1 |
| أكثر من 40 سنة | 0.08 x العمر | |
| Invasion غزو الورم للمناطق المحيطة بالعنق الظاهر بالعين المجردة | نعم | 1 |
| لا | 0 | |
| Completeness اكتمال استئصال الورم جراحياً | غير مكتملة | 1 |
| مكتملة | 0 | |
| Size حجم الورم | 0.3 x الحجم بالسم | |
| مجموع نقاط MACIS [30] | البقاء 20 سنة [30] |
|---|---|
| < 6.0 | 99% |
| 6.0 - 6.99 | 89% |
| 7.0 - 7.99 | 56% |
| > 8.0 | 24% |
يُدرج معظم المرضى تحت تصنيف الخطر المنخفض (بنقاط أقل من 6.0) ويشفون من السرطان وقت الجراحة.[30]
الأطفال المصابون بالانبثاث الرئوي المتعددة و/أو miliary aspect لا تزال توقعات سير المرض لديهم ممتازة على المدى الطويل إذا تلقوا العلاج الكافي.[31]
المرحلة
تبعاً لتحديد مرحلة السرطان في المراحل 1 إلى 4، يصل معدل البقاء لخمس سنوات لسرطان الدرقية 100% للمرحلة 1 و2، 93% للمرحلة 3 و51 للمرحلة الرابعة.[32]
الانتشار
حسب الترصد، علم الأوبئة، والنتائج النهائية (SEER)، فقد ارتفع معدل الإصابة بالسرطان الحليمي من 4.8 إلى 14.9 لكل 100،000 شخص من عام 1975 حتى عام 2012. من المرجح أن تصاب الإناث بسرطان حليمي مقارنة بالذكور مع نسبة الإصابة من 2.5 إلى 1 حيث يتم تشخيص معظم أنواع السرطان بين 40 و50 عاماً في الإناث.[33] تزايد معدلات الإصابة بعد العلاج الإشعاعي مهملة. التعرض البيئي للأشعة مثل الهجوم النووي على هيروشيما وناگاساكي وكارثة تشرنوبل تسببتا أيضاً في زيادة حالت سرطان الغدة الدرقية الحليمي لدى الأطفال بعد 2-20 سنة من التعرض للإشعاع.[34] التاريخ العائلي لمتلازمة سرطان الغدة الدرقية مثل داء السلائل الورمي الغدي العائلي، متلازمة كارني، تكون الورم الصماوي المتعدد النوع 2 (MEN-2)، متلازمة ورنر، ومتلازمة كاودن تزيد معدل الإصابة بالسرطان الحليمي.[33]
المصادر
- ^ أ ب ت ث ج ح Chapter 20 in: Mitchell, Richard Sheppard; Kumar, Vinay; Abbas, Abul K; Fausto, Nelson (2007). Robbins Basic Pathology. Philadelphia: Saunders. ISBN 978-1-4160-2973-1. 8th edition.
- ^ Hu MI, Vassilopoulou-Sellin R, Lustig R, Lamont JP "Thyroid and Parathyroid Cancers" in Pazdur R, Wagman LD, Camphausen KA, Hoskins WJ (Eds) Cancer Management: A Multidisciplinary Approach. 11 ed. 2008.
- ^ Dinets A, Hulchiy M, Sofiadis A, Ghaderi M, Höög A, Larsson C, Zedenius J (2012). "Clinical, Genetic and Immunohistochemical Characterization of 70 Ukrainian Adult Cases with Post-Chornobyl Papillary Thyroid Carcinoma". Eur J Endocrinol. 166 (6): 1049–60. doi:10.1530/EJE-12-0144. PMC 3361791. PMID 22457234.
- ^ "Papillary Thyroid Carcinoma: An Overview". Archives of Pathology & Laboratory Medicine. 2006. Retrieved 2010-07-15.
- ^ أ ب ت "The Thyroid and its Diseases". Archived from the original on 2010-07-01. Retrieved 2010-07-15.
{{cite web}}: Unknown parameter|deadurl=ignored (|url-status=suggested) (help) - ^ Surgical Recall 7th Edition ISBN 978-1451192919
- ^ Lin JD (2007). "Thyroglobulin and human thyroid cancer". Clin Chim Acta. 388 (1–2): 15–21. doi:10.1016/j.cca.2007.11.002. PMID 18060877.
- ^ Tuttle RM, Leboeuf R, Martorella AJ (2007). "Papillary thyroid cancer: monitoring and therapy". Endocrinol. Metab. Clin. North Am. 36 (3): 753–78, vii. doi:10.1016/j.ecl.2007.04.004. PMID 17673127.
- ^ Papotti M, Rodriguez J, De Pompa R, Bartolazzi A, Rosai J (April 2005). "Galectin-3 and HBME-1 expression in well-differentiated thyroid tumors with follicular architecture of uncertain malignant potential". Mod. Pathol. 18 (4): 541–46. doi:10.1038/modpathol.3800321. PMID 15529186.
- ^ Hurtado-López, LM; Fernández-Ramírez, F; Martínez-Peñafiel, E; Carrillo Ruiz, JD; Herrera González, NE (16 June 2015). "Molecular Analysis by Gene Expression of Mitochondrial ATPase Subunits in Papillary Thyroid Cancer: Is ATP5E Transcript a Possible Early Tumor Marker?". Medical Science Monitor : International Medical Journal of Experimental and Clinical Research. 21: 1745–51. doi:10.12659/MSM.893597. PMC 4482184. PMID 26079849.
- ^ "Papillary Carcinoma of Thyroid (Hi Pow)". University of Connecticut Health Center. Archived from the original on 2012-07-09. Retrieved 2008-09-14.
{{cite web}}: Unknown parameter|deadurl=ignored (|url-status=suggested) (help) - ^ Yang GC, Liebeskind D, Messina AV (2001). "Ultrasound-guided fine-needle aspiration of the thyroid assessed by Ultrafast Papanicolaou stain: data from 1135 biopsies with a two- to six-year follow-up". Thyroid. 11 (6): 581–89. doi:10.1089/105072501750302895. PMID 11442006.
- ^ Escofet X, Khan AZ, Mazarani W, Woods WG (2007). "Lessons to be learned: a case study approach. Lateral aberrant thyroid tissue: is it always malignant?". J R Soc Health. 127 (1): 45–6. doi:10.1177/1466424007073207. PMID 17319317.
- ^ Shaha AR (2007). "TNM classification of thyroid carcinoma". World J Surg. 31 (5): 879–87. doi:10.1007/s00268-006-0864-0. PMID 17308849.
- ^ Harach HR, Franssila KO, Wasenius VM (1985). "Occult papillary carcinoma of the thyroid. A "normal" finding in Finland. A systematic autopsy study". Cancer. 56 (3): 531–8. doi:10.1002/1097-0142(19850801)56:3<531::AID-CNCR2820560321>3.0.CO;2-3. PMID 2408737.
- ^ Pakdaman MN, Rochon L, Gologan O, Tamilia M, Garfield N, Hier MP, Black MJ, Payne RJ (2008). "Incidence and histopathological behavior of papillary microcarcinomas: Study of 429 cases". Otolaryngol Head Neck Surg. 139 (5): 718–22. doi:10.1016/j.otohns.2008.08.014. PMID 18984270.
- ^ Woolner LB, Lemmon ML, Beahrs OH, Black BM, Keating FR (January 1960). "Occult papillary carcinoma of the thyroid gland: a study of 140 cases observed in a 30-year period". J. Clin. Endocrinol. Metab. 20: 89–105. doi:10.1210/jcem-20-1-89. PMID 13845950.
- ^ "Nomenclature Revision for encapsulated follicular variant of papillary thyroid carcinoma: A Paradigm Shift to Reduce Overtreatment of Indolent Tumors". JAMA Oncol. 2 (8): 1023–9. 14 April 2016. doi:10.1001/jamaoncol.2016.0386. PMC 5539411. PMID 27078145.
{{cite journal}}: Cite uses deprecated parameter|authors=(help) - ^ "Thyroid, Papillary Carcinoma". Retrieved 2010-07-15.
- ^ Grani, G; Fumarola, A (Jun 2014). "Thyroglobulin in Lymph Node Fine-Needle Aspiration Washout: A Systematic Review and Meta-analysis of Diagnostic Accuracy". The Journal of Clinical Endocrinology and Metabolism. 99 (6): 1970–82. doi:10.1210/jc.2014-1098. PMID 24617715.
- ^ "Papillary Carcinomas". Archived from the original on April 19, 2010. Retrieved 2010-07-15.
{{cite web}}: Unknown parameter|deadurl=ignored (|url-status=suggested) (help) - ^ Cooper, David (November 2009). "Revised American Thyroid Association management guidelines for patients with thyroid nodules and differentiated thyroid cancer" (PDF). Thyroid. 19 (11): 1167–1214. doi:10.1089/thy.2009.0110. hdl:2027.42/78131. PMID 19860577.
- ^ Udelsman, Robert (July 2005). "Is total thyroidectomy the best possible surgical management for well-differentiated thyroid cancer?". The Lancet Oncology. 6 (7): 529–531. doi:10.1016/s1470-2045(05)70247-3. PMID 15992702.
- ^ "Treatment". Retrieved 2010-07-15.
- ^ "Papillary Thyroid Carcinoma". Archived from the original on July 19, 2008. Retrieved 2010-07-15.
{{cite web}}: Unknown parameter|deadurl=ignored (|url-status=suggested) (help) - ^ Adam, Mohamed (January 2015). "Impact of extent of surgery on survival for papillary thyroid cancer patients younger than 45 years". J Clin Endocrinol Metab. 100 (1): 115–121. doi:10.1210/jc.2014-3039. PMC 5399499. PMID 25337927.
- ^ أ ب Numbers from National Cancer Database in the US, from Page 10 in: Biersack, H-J; Grünwald, F, eds. (2005). Thyroid Cancer. Berlin: Springer. ISBN 978-3-540-22309-2. (Note: Book also states that the 14 percent 10-year survival for anaplastic thyroid cancer was overestimated)
- ^ Rounded up to nearest natural number from 96.7 percent as given by eMedicine > Thyroid, Papillary Carcinoma Author: Luigi Santacroce. Coauthors: Silvia Gagliardi and Andrew Scott Kennedy. Updated: Sep 28, 2010
- ^ "New York Thyroid Center: Prognosis Staging for Thyroid Cancer". Archived from the original on 2007-12-14. Retrieved 2007-12-22.
{{cite web}}: Unknown parameter|deadurl=ignored (|url-status=suggested) (help) - ^ أ ب ت ث ج ح New York Thyroid Center > Thyroid cancer > Prognosis staging Retrieved on April 30, 2010
- ^ Vermeer-Mens, J. C. J.; Goemaere, N. N. T.; Kuenen-Boumeester, V.; De Muinck Keizer-Schrama, S. M. P. F.; Zwaan, C. M.; Devos, A. S.; De Krijger, R. R. (2006). "Childhood Papillary Thyroid Carcinoma with Miliary Pulmonary Metastases". Journal of Clinical Oncology. 24 (36): 5788–5789. doi:10.1200/JCO.2006.08.8732. PMID 17179115. [1]
- ^ cancer.org > Thyroid Cancer By the American Cancer Society. In turn citing: AJCC Cancer Staging Manual (7th ed).
- ^ أ ب Tuttle, RM; Ross, DS; Mulder, JE. "Papillary thyroid cancer". UpToDate. Retrieved 13 October 2017.
- ^ Vaisman, F; Corbo, R; Vaisman, M (9 May 2011). "Thyroid Carcinoma in Children and Adolescents—Systematic Review of the Literature". Journal of Thyroid Research. 2011: 845362. doi:10.4061/2011/845362. PMC 3166725. PMID 21904689.
{{cite journal}}: CS1 maint: unflagged free DOI (link)
وصلات خارجية
| Classification | |
|---|---|
| External resources |